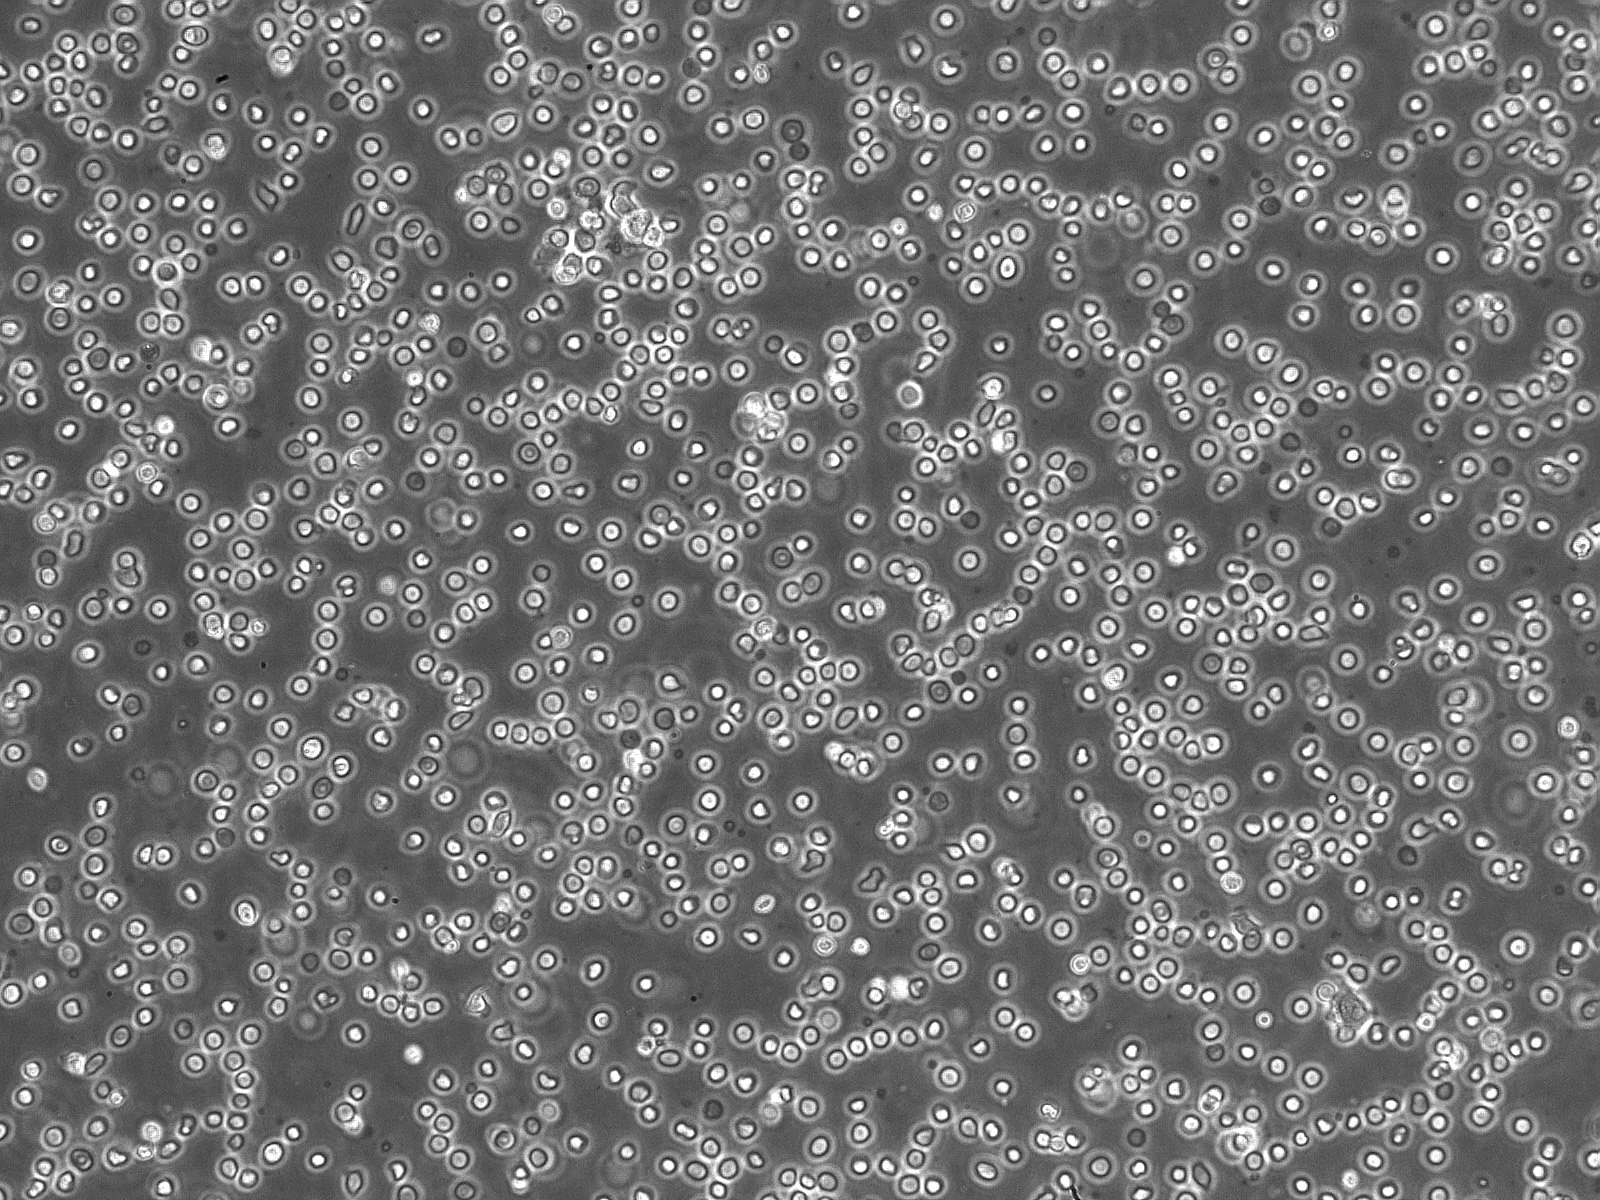

Human Lymphatic Mononuclear Cells
Product Code:
SC-2540
SC-2540
Cell System:
Lymphatic Cell System
Lymphatic Cell System
Cell Type:
Mononuclear Cells
Mononuclear Cells
Species:
Human
Human
Regulatory Status:
RUO
RUO
Shipping:
Dry Ice
Dry Ice
Storage:
Liquid Nitrogen
Liquid Nitrogen
No additional charges, what you see is what you pay! *
| Code | Size | Price |
|---|
| SC-2540 | 10 x 10^6 cells/vial | £764.00 |
Prices exclude any Taxes / VAT